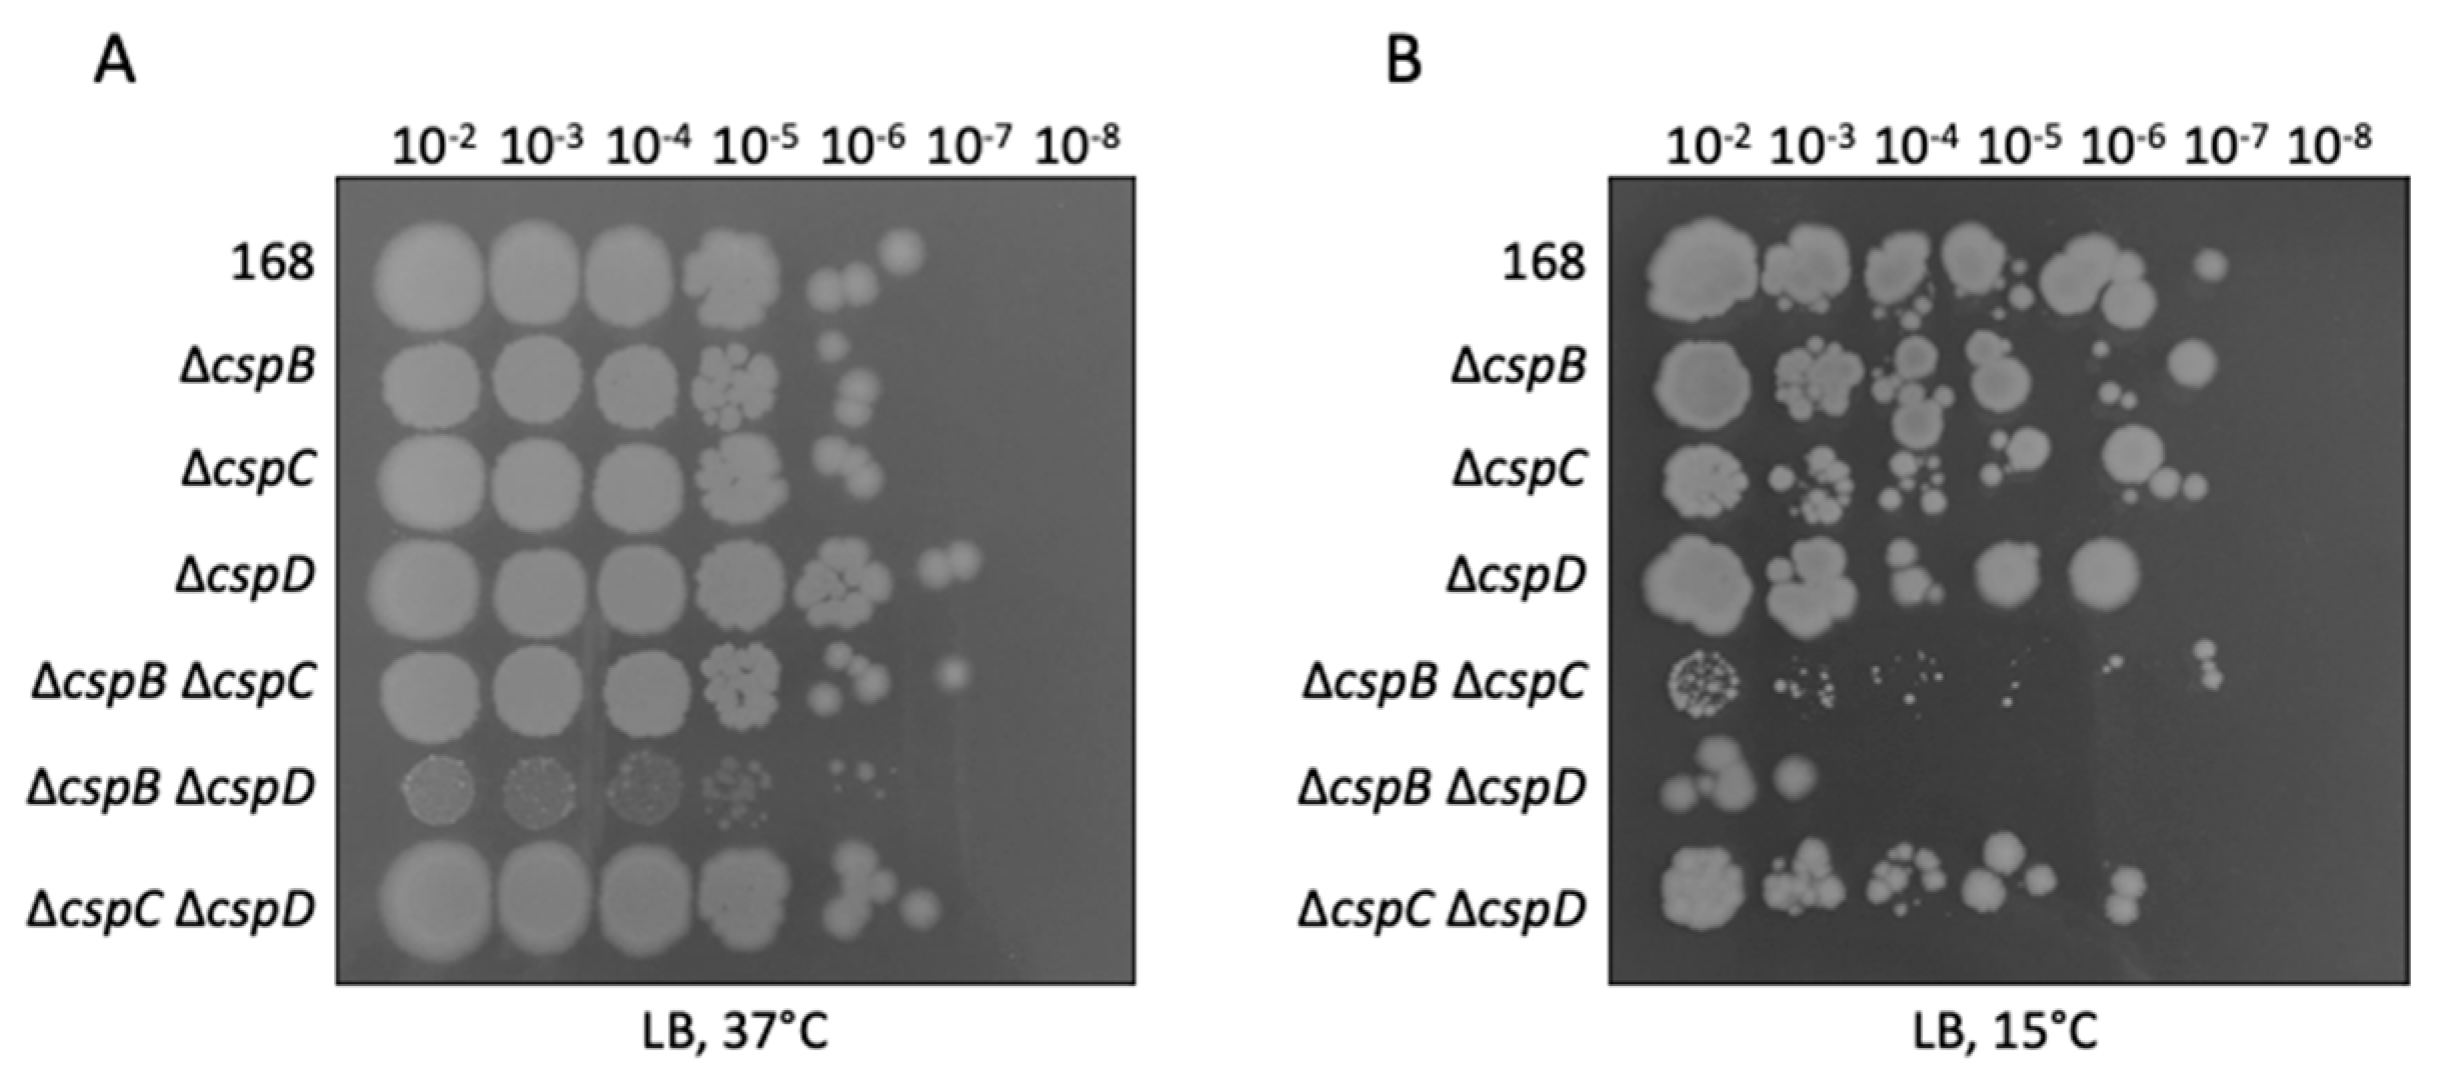
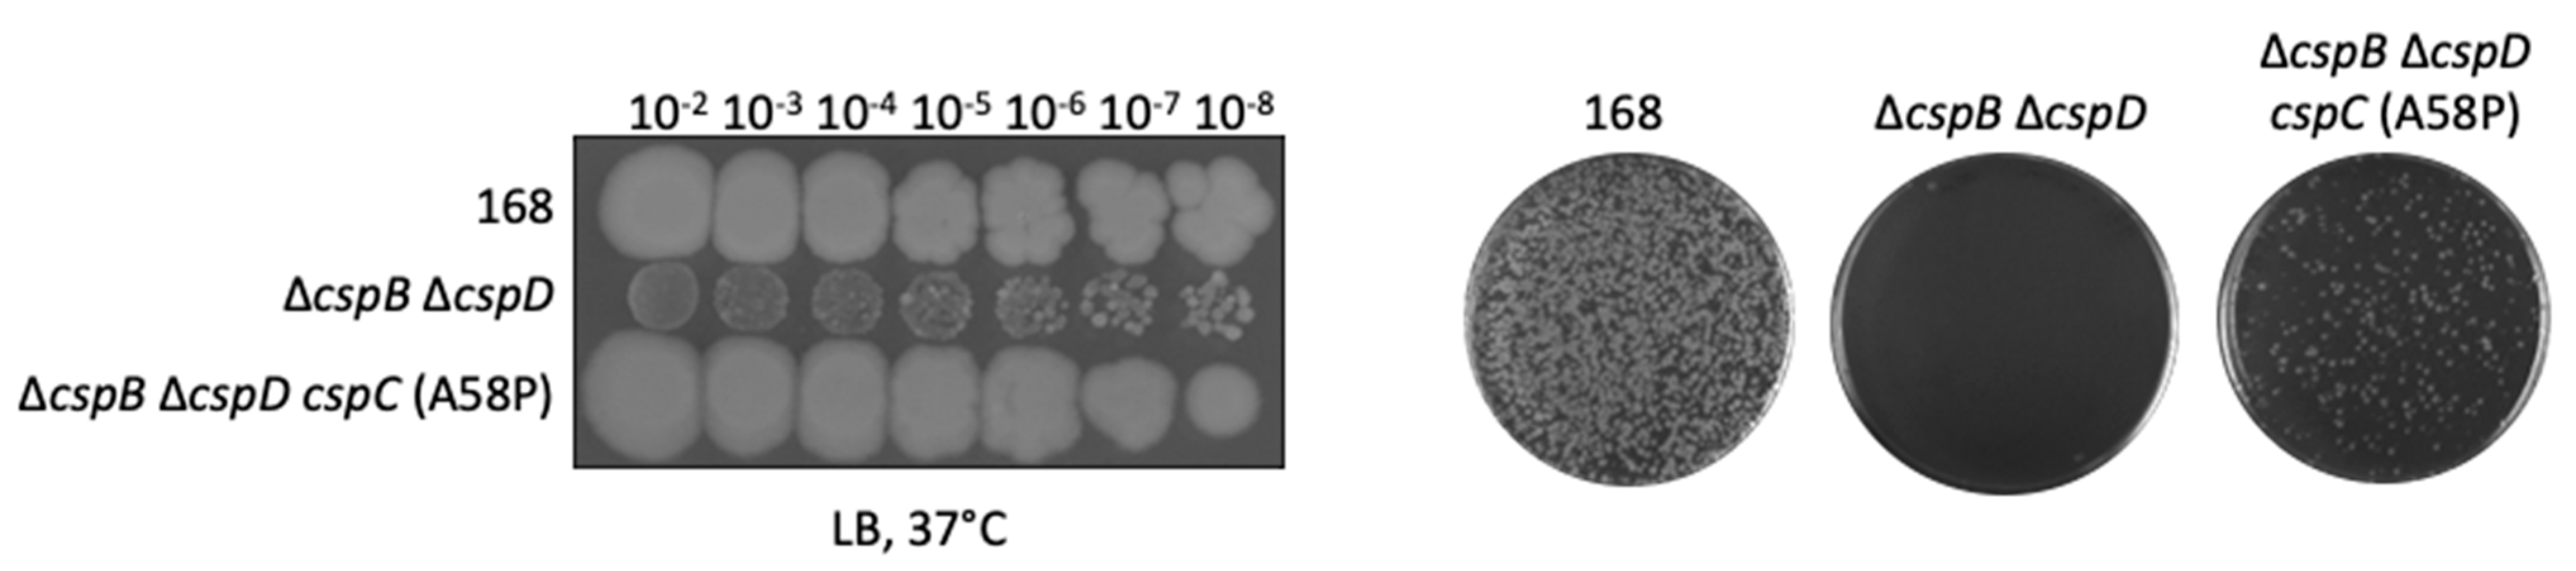

Functional Redundancy and Specialization of the Conserved Cold Shock Proteins in Bacillus subtilis
Abstract
1. Introduction
2. Materials and Methods
2.1. Bacterial Strains, Growth Conditions, and Phenotypic Characterization
2.2. DNA Manipulation and Genome Sequencing
2.3. Construction of Translational LacZ Reporter Gene Fusions
2.4. Construction of Mutants
2.5. RNA-Sequencing
2.6. Qualitative PCR and Real-Time Quantitative Reverse Transcription PCR
2.7. Microscopy
3. Results
3.1. Relative Contribution of the Cold Shock Proteins to the Growth of B. subtilis
3.2. Suppressor Analysis of the CspB CspD Double Mutant
3.3. A Modified CspC Protein Can Take over the Functions of CspB and CspD
3.4. RNA-Seq Analysis Suggests a Role for Cold Shock Proteins in Transcription Termination and Elongation
3.5. Analysis of Csp-Dependent Transcription Read-Through
4. Discussion
Supplementary Materials
Author Contributions
Funding
Institutional Review Board Statement
Informed Consent Statement
Data Availability Statement
Acknowledgments
Conflicts of Interest
References
- Michna, R.H.; Zhu, B.; Mäder, U.; Stülke, J. SubtiWiki 2.0—An integrated database for the model organism Bacillus subtilis. Nucleic Acids Res. 2016, 44, D654–D662. [Google Scholar] [CrossRef] [PubMed][Green Version]
- Hutchison, C.A.; Chuang, R.Y.; Noskov, V.N.; Assad-Garcia, N.; Deerinck, T.J.; Ellisman, M.H.; Gill, J.; Kannan, K.; Karas, B.J.; Ma, L.; et al. Design and synthesis of a minimal bacterial genome. Science 2016, 351, aad6253. [Google Scholar] [CrossRef] [PubMed]
- Reuß, D.R.; Altenbuchner, J.; Mäder, U.; Rath, H.; Ischebeck, T.; Sappa, P.K.; Thürmer, A.; Guérin, C.; Nicolas, P.; Steil, L.; et al. Large-scale reduction of the Bacillus subtilis genome: Consequences for the transcriptional network, resource allocation, and metabolism. Genome Res. 2017, 27, 289–299. [Google Scholar] [CrossRef]
- Eymann, C.; Dreisbach, A.; Albrecht, D.; Bernhardt, J.; Becher, D.; Gentner, S.; Tam, L.T.; Büttner, K.; Buurman, G.; Scharf, C.; et al. A comprehensive proteome map of growing Bacillus subtilis cells. Proteomics 2004, 4, 2849–2876. [Google Scholar] [CrossRef]
- Graumann, P.; Wendrich, T.M.; Weber, M.H.W.; Schröder, K.; Marahiel, M.A. A family of cold shock proteins in Bacillus subtilis is essential for cellular growth and for efficient protein synthesis at optimal and low temperatures. Mol. Microbiol. 1997, 25, 741–756. [Google Scholar] [CrossRef] [PubMed]
- Feliciano, J.R.; Seixas, A.M.M.; Pita, T.; Leitao, J.H. Comparative genomics and evolutionary analysis of RNA-binding proteins of Burkholderia cenocepacia J2315 and other members of the B. cepacia complex. Genes 2020, 11, 231. [Google Scholar] [CrossRef]
- Nicolas, P.; Mäder, U.; Dervyn, E.; Rochat, T.; Leduc, A.; Pigeonneau, N.; Bidnenko, E.; Marchadier, E.; Hoebeke, M.; Aymerich, S.; et al. Condition-dependent transcriptome reveals high-level regulatory architecture in Bacillus subtilis. Science 2012, 335, 1103–1106. [Google Scholar] [CrossRef]
- Gebhard, S. ABC transporters of antimicrobial peptides in Firmicutes bacteria—Phylogeny, function and regulation. Mol. Microbiol. 2012, 86, 1295–1317. [Google Scholar] [CrossRef] [PubMed]
- Krüger, L.; Herzberg, C.; Rath, H.; Pedreira, T.; Ischebeck, T.; Poehlein, A.; Gundlach, J.; Daniel, R.; Völker, U.; Mäder, U.; et al. Essentiality of c-di-AMP in Bacillus subtilis: Bypassing mutations converge in potassium and glutamate homeostasis. PLoS Genet. 2021, 17, e1009092. [Google Scholar] [CrossRef] [PubMed]
- Klewing, A.; Koo, B.M.; Krüger, L.; Poehlein, A.; Reuß, D.; Daniel, R.; Gross, C.A.; Stülke, J. Resistance to serine in Bacillus subtilis: Identification of the serine transporter YbeC and of a metabolic network that links serine and threonine metabolism. Environ. Microbiol. 2020, 22, 3937–3949. [Google Scholar] [CrossRef] [PubMed]
- Commichau, F.M.; Heidemann, J.L.; Ficner, R.; Stülke, J. Making and breaking of an essential poison: The cyclases and phosphodiesterases that produce and degrade the essential second messenger cyclic di-AMP in bacteria. J. Bacteriol. 2019, 201, e00462-18. [Google Scholar] [CrossRef] [PubMed]
- Mehne, F.M.P.; Schröder-Tittmann, K.; Eijlander, R.T.; Herzberg, C.; Hewitt, L.; Kaever, V.; Lewis, R.J.; Kuipers, O.P.; Tittmann, K.; Stülke, J. Control of the diadenylate cyclase CdaS in Bacillus subtilis: An autoinhibitory domain limits c-di-AMP production. J. Biol. Chem. 2014, 289, 21098–21107. [Google Scholar] [CrossRef] [PubMed]
- Lehnik-Habrink, M.; Rempeters, L.; Kovács, Á.; Wrede, C.; Baierlein, C.; Krebber, H.; Kuipers, O.P.; Stülke, J. The DEAD-box RNA helicases in Bacillus subtilis have multiple functions and act independent from each other. J. Bacteriol. 2013, 195, 534–544. [Google Scholar] [CrossRef]
- Procaccini, A.; Lunt, B.; Szurmant, H.; Hwa, T.; Weight, M. Dissecting the specificity of protein-protein interaction in bacterial two-component signaling: Orphans and crosstalks. PLoS ONE 2011, 6, e19729. [Google Scholar] [CrossRef] [PubMed]
- Helmann, J.D. Bacillus subtilis extracytoplasmic function (ECF) sigma factors and defense of the cell envelope. Curr. Opin. Microbiol. 2016, 30, 122–132. [Google Scholar] [CrossRef] [PubMed]
- Schilling, O.; Herzberg, C.; Hertrich, T.; Vörsmann, H.; Jessen, D.; Hübner, S.; Titgemeyer, F.; Stülke, J. Keeping signals straight in transcription regulation: Specificity determinants for the interaction of a family of conserved bacterial RNA-protein couples. Nucleic Acids Res. 2006, 34, 6102–6115. [Google Scholar] [CrossRef]
- Pané-Farré, J.; Lewis, R.J.; Stülke, J. The RsbRST stress module in bacteria: A signalling system that may interact with different output modules. J. Mol. Microbiol. Biotechnol. 2005, 9, 65–76. [Google Scholar] [CrossRef] [PubMed]
- Catalan-Moreno, A.; Caballero, C.J.; Irurzun, N.; Cuesta, S.; López-Sagaseta, J.; Toledo-Arana, A. One evolutionary selected amino acid variation is sufficient to provide functional specificity in the cold shock protein paralogs of Staphylococcus aureus. Mol. Microbiol. 2020, 113, 826–840. [Google Scholar] [CrossRef] [PubMed]
- Catalan-Moreno, A.; Cela, M.; Mendenez-Gil, P.; Irurzun, N.; Caballero, C.J.; Caldelari, I.; Toledo-Arana, A. RNA thermoswitches modulate Staphylococcus aureus adaptation to ambient temperatures. Nucleic Acids Res. 2021, 49, 3409–3426. [Google Scholar] [CrossRef]
- Kunst, F.; Rapoport, G. Salt stress is an environmental signal affecting degradative enzyme synthesis in Bacillus subtilis. J. Bacteriol. 1995, 177, 2403–2407. [Google Scholar] [CrossRef]
- Sambrook, J.; Fritsch, E.F.; Maniatis, T. Molecular Cloning: A Laboratory Manual, 2nd ed.; Cold Spring Harbor Laboratory: Cold Spring Harbor, NY, USA, 1989. [Google Scholar]
- Lamm-Schmidt, V.; Fuchs, M.; Sulzer, J.; Gerovac, M.; Hör, J.; Dersch, P.; Vogel, J.; Faber, F. Grad-seq identifies KhpB as a global RNA-binding protein in Clostrioides difficile that regulates toxin production. microLife 2021, 2, uqab004. [Google Scholar] [CrossRef]
- Barbe, V.; Cruveiller, S.; Kunst, F.; Lenoble, P.; Meurice, G.; Sekowska, A.; Vallenet, D.; Wang, T.; Moszer, I.; Médigue, C.; et al. From a consortium sequence to a unified sequence: The Bacillus subtilis 168 reference genome a decade later. Microbiology 2009, 155, 1758–1775. [Google Scholar] [CrossRef]
- Kearse, M.; Moir, R.; Wilson, A.; Stones-Havas, S.; Cheung, M.; Sturrock, S.; Buxton, S.; Cooper, A.; Markowitz, S.; Duran, C.; et al. Geneious basic: An integrated and extendable desktop software platform for the organization and analysis of sequence data. Bioinformatics 2012, 28, 1647–1649. [Google Scholar] [CrossRef] [PubMed]
- Martin-Verstraete, I.; Débarbouillé, M.; Klier, A.; Rapoport, G. Mutagenesis of the Bacillus subtilis “-12, -24” promoter of the levanase operon and evidence for the existence of an upstream activating sequence. J. Mol. Biol. 1992, 226, 85–99. [Google Scholar] [CrossRef]
- Lehnik-Habrink, M.; Pförtner, H.; Rempeters, L.; Pietack, N.; Herzberg, C.; Stülke, J. The RNA degradosome in Bacillus subtilis: Identification of CshA as the major helicase in the multiprotein complex. Mol. Microbiol. 2010, 77, 958–971. [Google Scholar] [CrossRef] [PubMed]
- Guérout-Fleury, A.M.; Shazand, K.; Frandsen, N.; Stragier, P. Antibiotic-resistance cassettes for Bacillus subtilis. Gene 1995, 167, 335–336. [Google Scholar] [CrossRef]
- Hames, C.; Halbedel, S.; Schilling, O.; Stülke, J. MMR: A method for the simultaneous introduction of multiple mutations into the glpK gene of Mycoplasma pneumoniae. Appl. Environ. Microbiol. 2005, 71, 4097–4100. [Google Scholar] [CrossRef] [PubMed]
- Langmead, B.; Trapnell, C.; Pop, M.; Salzberg, S.L. Ultrafast and memory-efficient alignment of short DNA sequences to the human genome. Genome Biol. 2009, 10, R25. [Google Scholar] [CrossRef] [PubMed]
- Love, M.I.; Huber, W.; Anders, S. Moderated estimation of fold change and dispersion for RNA-seq data with DESeq2. Genome Biol. 2014, 15, 550. [Google Scholar] [CrossRef] [PubMed]
- Hilker, R.; Stadermann, K.B.; Schwengers, O.; Anisiforov, E.; Jaenicke, S.; Weisshaar, B.; Zimmermann, T.; Goesmann, A. ReadXplorer 2—Detailed read mapping analysis and visualization from one single source. Bioinformatics 2016, 32, 3702–3708. [Google Scholar] [CrossRef] [PubMed]
- Schilling, O.; Frick, O.; Herzberg, C.; Ehrenreich, A.; Heinzle, E.; Wittmann, C.; Stülke, J. Transcriptional and metabolic responses of Bacillus subtilis to the availability of organic acids: Transcription regulation is important but not sufficient to account for metabolic adaptation. Appl. Environ. Microbiol. 2007, 73, 499–507. [Google Scholar] [CrossRef] [PubMed]
- Diethmaier, C.; Pietack, N.; Gunka, K.; Wrede, C.; Lehnik-Habrink, M.; Herzberg, C.; Hübner, S.; Stülke, J. A novel factor controlling bistability in Bacillus subtilis: The YmdB protein affects flagellin expression and biofilm formation. J. Bacteriol. 2011, 193, 5997–6007. [Google Scholar] [CrossRef] [PubMed]
- Mehne, F.M.P.; Gunka, K.; Eilers, H.; Herzberg, C.; Kaever, V.; Stülke, J. Cyclic-di-AMP homeostasis in Bacillus subtilis: Both lack and high-level accumulation of the nucleotide are detrimental for cell growth. J. Biol. Chem. 2013, 288, 2004–2017. [Google Scholar] [CrossRef] [PubMed]
- Zhao, H.; Sun, Y.; Peters, J.M.; Gross, C.A.; Garner, E.C.; Helmann, J.D. Depletion of undecaprenyl phosphatases disrupts cell envelope biogenesis in Bacillus subtilis. J. Bacteriol. 2016, 198, 2925–2935. [Google Scholar] [CrossRef]
- Bae, W.; Xia, B.; Inouye, M.; Severinov, K. Escherichia coli CspA-family RNA chaperones are transcription antiterminators. Proc. Natl. Acad. Sci. USA 2000, 97, 7784–7789. [Google Scholar] [CrossRef] [PubMed]
- Switzer, R.L.; Turner, R.J.; Lu, Y. Regulation of the Bacillus subtilis pyrimidine biosynthetic operon by transcriptional attenuation: Control of gene expression by an mRNA-binding protein. Prog. Nucleic Acid Res. Mol. Biol. 1999, 62, 329–367. [Google Scholar] [PubMed]
- Galperin, M.Y.; Wolf, Y.I.; Makarova, K.S.; Vera Alvarez, R.; Landsman, D.; Koonin, E.V. COG database update: Focus on microbial diversity, model organisms, and widespread pathogens. Nucleic Acids Res. 2021, 49, D274–D281. [Google Scholar] [CrossRef]
- Commichau, F.M.; Pietack, N.; Stülke, J. Essential genes in Bacillus subtilis: A re-evaluation after ten years. Mol. BioSyst. 2013, 9, 1068–1075. [Google Scholar] [CrossRef]
- Reuß, D.R.; Commichau, F.M.; Gundlach, J.; Zhu, B.; Stülke, J. The blueprint of a minimal cell: MiniBacillus. Microbiol. Mol. Biol. Rev. 2016, 80, 955–987. [Google Scholar] [CrossRef]
- Reuß, D.R.; Faßhauer, P.; Mroch, P.J.; Ul-Haq, I.; Koo, B.M.; Poehlein, A.; Gross, C.A.; Daniel, R.; Brantl, S.; Stülke, J. Topoisomerase IV can functionally replace all type 1A topoisomerases in Bacillus subtilis. Nucleic Acids Res. 2019, 47, 5231–5242. [Google Scholar] [CrossRef] [PubMed]
- Lei, Y.; Oshima, T.; Ogasawara, N.; Ishikawa, S. Functional analysis of the protein Veg, which stimulates biofilm formation in Bacillus subtilis. J. Bacteriol. 2013, 195, 1697–1705. [Google Scholar] [CrossRef] [PubMed]
- Giangrossi, M.; Brandi, A.; Gioliodori, A.M.; Gualerzi, C.O.; Pon, C.L. Cold-shock-induced de novo transcription and translation of infA and role of IF1 during cold adaptation. Mol. Microbiol. 2007, 64, 807–821. [Google Scholar] [CrossRef] [PubMed]
- Benda, M.; Woelfel, S.; Fasshauer, P.; Gunka, K.; Klumpp, S.; Poehlein, A.; Kálalová, D.; Šanderová, H.; Daniel, R.; Krásný, L.; et al. Quasi-essentiality of RNase Y in Bacillus subtilis is caused by its critical role in the control of mRNA homeostasis. Nucleic Acids Res. 2021. [Google Scholar] [CrossRef] [PubMed]

| Strain | Genotype | Source or Reference |
|---|---|---|
| 168 | trpC2 | Laboratory collection |
| GP1968 | trpC2 ΔcspB::cat | This study |
| GP1969 | trpC2 ΔcspC::spec | This study |
| GP1970 | trpC2 ΔcspB::cat ΔcspC::spec | This study |
| GP1971 | trpC2 ΔcspB::cat ΔcspD::aphA3 | This study |
| GP1972 | trpC2 ΔcspC::spec ΔcspD::aphA3 | This study |
| GP1984 | trpC2 amyE::(PcspC-lacZ cat) | pGP3117→168 |
| GP1986 | trpC2 amyE::(PcspC[G-65A]-lacZ cat) | pGP3119→168 |
| GP1989 1 | trpC2 ΔcspB::cat ΔcspD::aphA3 PcspC-[G-65A] | This study |
| GP1990 1 | trpC2 ΔcspB::cat ΔcspD::aphA3 Pveg-[G-10T] | This study |
| GP2614 | trpC2 ΔcspD::aphA3 | [22] |
| GP2888 | trpC2 Δveg::ermC | This study |
| GP2896 | trpC2 Δveg::ermC ΔcspD::aphA3 | GP2888→GP2614 |
| GP2897 | trpC2 Δveg::ermC ΔcspB::cat ΔcspD::aphA3 | GP1968→GP2896 |
| GP2898 | trpC2 amyE::(Pveg-lacZ cat) | pGP3133→168 |
| GP2899 | trpC2 amyE::(Pveg-[G-10T]-lacZ cat) | pGP3134→168 |
| GP2900 1 | trpC2 ΔcspB::cat ΔcspD::aphA3 degS[P245S] | This study |
| GP3251 | trpC2 ΔcspB::tet | This study |
| GP3274 | trpC2 cspC-A58P-spec ΔcspD::aphA3 | This study |
| GP3275 | trpC2 cspC-A58P-spec ΔcspB::tet ΔcspD::aphA3 | GP3251→GP3274 |
| GP3283 | trpC2 amyE::(PcspB-lacZ cat) | pGP3136→168 |
| GP3286 | trpC2 amyE::(PcspD-lacZ-cat) | This study |
| Strain | Promoter | Enzyme Activity in Units/Mg of Protein a | |
|---|---|---|---|
| 15 °C | 37 °C | ||
| GP3283 | cspB | 14,900 ± 1680 | 11,750 ± 560 |
| GP1984 | cspC | 30,950 ± 2900 | 6320 ± 280 |
| GP3286 | cspD | 11,300 ± 1600 | 19,600 ± 450 |
| Transcription Unit | Function 1 | Remarks | Fold Regulation Upon cspB cspD Deletion |
|---|---|---|---|
| mRNAs with increased amounts upon deletion of cspB and cspD | |||
| liaIH | Resistance against cell wall antibiotics | Activated by LiaR | 150 |
| rbsACB | Ribose utilization | Repressed by CcpA | 110 |
| maeN | Malate uptake | Activated by MalR | 62 |
| tlpA | Chemotaxis receptor | SigD regulon | 47 |
| ywsB | General stress protein | SigB regulon | 45 |
| manPA-yjdF | Mannose utilization | Activated by ManR | 36 |
| yodTSR | Spore metabolism | SigE regulon | 32 |
| yorR | Unknown, SPβ prophage | 30 | |
| ybdN | Unknown | Repressed by AbrB | 23 |
| uxaC | Hexuronate utilization | Repressed by ExuR and CcpA | 21 |
| mRNAs with decreased amounts upon deletion of cspB and cspD | |||
| cydABCD | Respiration, cytochrome bd oxidase | Repressed by CcpA and Rex | −640 |
| ldh-lctP | Overflow metabolism | Repressed by Rex | −530 |
| narGHJI | Nitrate respiration | Activated by Fnr | −210 |
| ywcJ | Putative nitrate channel | Repressed by Rex | −163 |
| arfM | Regulation of anaerobic genes | Activated by Fnr | −90 |
| mhqNOP | Resistance against oxidative stress | Repressed by MhqR | −64 |
| cotJC | Spore coat protein | SigE regulon | −35 |
Publisher’s Note: MDPI stays neutral with regard to jurisdictional claims in published maps and institutional affiliations. |
© 2021 by the authors. Licensee MDPI, Basel, Switzerland. This article is an open access article distributed under the terms and conditions of the Creative Commons Attribution (CC BY) license (https://creativecommons.org/licenses/by/4.0/).
Share and Cite
Faßhauer, P.; Busche, T.; Kalinowski, J.; Mäder, U.; Poehlein, A.; Daniel, R.; Stülke, J. Functional Redundancy and Specialization of the Conserved Cold Shock Proteins in Bacillus subtilis. Microorganisms 2021, 9, 1434. https://doi.org/10.3390/microorganisms9071434
Faßhauer P, Busche T, Kalinowski J, Mäder U, Poehlein A, Daniel R, Stülke J. Functional Redundancy and Specialization of the Conserved Cold Shock Proteins in Bacillus subtilis. Microorganisms. 2021; 9(7):1434. https://doi.org/10.3390/microorganisms9071434
Chicago/Turabian StyleFaßhauer, Patrick, Tobias Busche, Jörn Kalinowski, Ulrike Mäder, Anja Poehlein, Rolf Daniel, and Jörg Stülke. 2021. "Functional Redundancy and Specialization of the Conserved Cold Shock Proteins in Bacillus subtilis" Microorganisms 9, no. 7: 1434. https://doi.org/10.3390/microorganisms9071434
APA StyleFaßhauer, P., Busche, T., Kalinowski, J., Mäder, U., Poehlein, A., Daniel, R., & Stülke, J. (2021). Functional Redundancy and Specialization of the Conserved Cold Shock Proteins in Bacillus subtilis. Microorganisms, 9(7), 1434. https://doi.org/10.3390/microorganisms9071434

